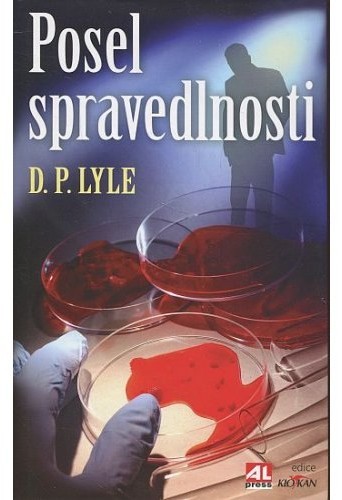

Detail knihy
Posel spravedlnosti
70,00 Kč
původní s přebalem 8°velmi dobrý2013sklad
Vlastnosti
Kategorie a produktové atributy
Taženo přímo z kategorií a globálních vlastností WooCommerce.
- Kategorie
- Detektivky / Thrillery
- Autor
- Lyle D.P.
- Místo vydání
- Frýdek-Místek
- Nakladatel
- Alpress
- Počet stran
- 320 s.
- Překlad
- Dalibor Míček
- Rok vydání
- 2013
- Sklad
- sklad
- Stav
- velmi dobrý
- Typ předmětu
- kniha
- Vazba
- původní s přebalem 8°
